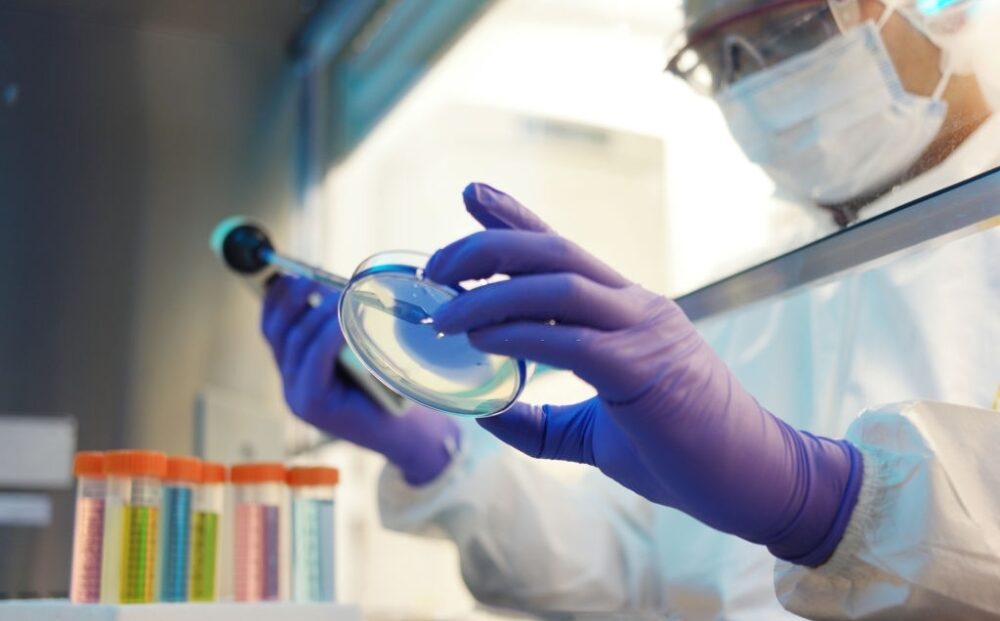
Scientist-working-in-a-cleanroom

Maximum Care for Your Health, Every Step of the Way

Committed to Excellence in Patient Care

Immediate Care When Every Second Matters
WELCOME TO NOBLE HOSPITAL
Committed to Ensuring Quality Healthcare
Get Appointment
Call US:
Visit Our Hospital
Address

Redefining Healthcare Standards with Expert Professionals
At Noble Hospital, we are committed to delivering exceptional healthcare with compassion, innovation, and integrity. Backed by years of medical expertise, we provide comprehensive healthcare services focused on accurate diagnosis, effective treatment, and complete patient satisfaction.
Our multidisciplinary team of doctors, nurses, and healthcare professionals works collaboratively to ensure personalized care and positive outcomes for every patient.
Have a look at our amazing medical services
Pediatrics
Microbiology
Radiology & Imaging
Nephrology
Pulmonology
Gastroenterology
Orthopedics
Cardiothoracic & Vascular Surgery (CTVS)
General Surgery

Our Scale of Care & Commitment to Excellence
The reasons to choose Noble Hospital
Hygienic & Safe Environment
Affordable & Transparent Billing
Experienced Specialists & Multispecialty Care
Meet Our Management Team
Our hospital is guided by a team of experienced healthcare leaders committed to clinical excellence, ethical practices, and patient-centered care. With decades of combined experience, our management ensures that every department operates with efficiency, transparency, and the highest standards of medical quality.
What happy patients say about Us
At Noble Hospital, excellence in healthcare has been our commitment for over 15 years. Patients trust us for comprehensive, compassionate, and advanced medical care.

Archana

Dinesh Sharma

Aman Kumar
Read our Health and wellness blog.
Book An Appointment
By submitting this form you are agreeing to our Privacy Policy,
We guarantee not to disclose your information.